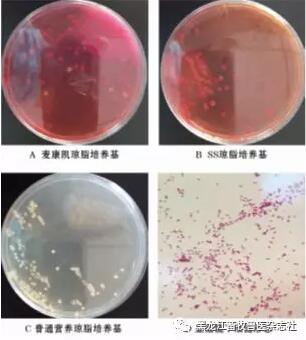

1、病例情況
河北省某原種豬場(chǎng)飼養(yǎng)基礎(chǔ)母豬1 200頭,仔豬轉(zhuǎn)到保育舍后陸續(xù)發(fā)病,保育豬發(fā)病后死亡率達(dá)5%。豬場(chǎng)采取常規(guī)藥物進(jìn)行治療,效果不明顯。免疫情況如下:1日齡滴鼻免疫豬偽狂犬活疫苗;7日齡免疫支原體疫苗;14日齡免疫豬圓環(huán)病毒病疫苗;21日齡免疫豬藍(lán)耳病疫苗; 40日齡免疫豬瘟疫苗;54日齡免疫傳染性胸膜肺炎疫苗;60日齡免疫豬偽狂犬病疫苗;70日齡免疫豬口蹄疫疫苗;90日齡免疫豬口蹄疫疫苗;120日齡免疫豬口蹄疫疫苗。
2、臨床癥狀
發(fā)病豬精神沉郁、食欲減退或廢絕,眼分泌物增多,呼吸困難、咳嗽、不愿站立。
3、病理剖檢
病豬全身有多發(fā)性漿膜炎,化膿性纖維蛋白滲出物覆蓋胸膜和腹膜上,呈纖維素性胸膜炎、心包炎,見(jiàn)圖1A;胸腔、腹腔積液增多;腹股溝淋巴結(jié)積液呈淡黃色膠凍樣,見(jiàn)圖1B;肺臟與胸膜黏連;膽囊腫大,膽汁濃稠;脾臟腫大、壞死,見(jiàn)圖1C;腎膜壞死、發(fā)黑,見(jiàn)圖1D;膀胱有少量出血點(diǎn);喉頭有出血;扁桃體充血。

圖1 病理剖檢結(jié)果
4、實(shí)驗(yàn)室診斷
4.1、病毒性病原檢測(cè)
采用PCR和RT-PCR法對(duì)仔豬進(jìn)行副豬嗜血桿菌、藍(lán)耳病病毒、豬瘟病毒、豬圓環(huán)病毒檢測(cè)。無(wú)菌采取發(fā)病仔豬心臟上纖維素性滲出物、扁桃體、肺臟、腎臟、脾臟等病變組織,研磨后進(jìn)行分子生物學(xué)檢測(cè),結(jié)果仔豬副豬嗜血桿菌、藍(lán)耳病病毒為陽(yáng)性,豬瘟病毒為陰性,豬圓環(huán)病毒為陰性,即從纖維滲出物和組織中檢測(cè)出副豬嗜血桿菌和藍(lán)耳病病毒。
4.2、細(xì)菌分離培養(yǎng)
用注射器無(wú)菌采取心包纖維素性滲出物,在無(wú)菌超凈工作臺(tái)中進(jìn)行細(xì)菌分離,分別接種到麥康凱瓊脂、SS瓊脂、普通營(yíng)養(yǎng)瓊脂培養(yǎng)基上,經(jīng)24h培養(yǎng)箱培養(yǎng)可見(jiàn)到細(xì)菌的生長(zhǎng),見(jiàn)圖2A~C。用接種環(huán)挑取營(yíng)養(yǎng)瓊脂培養(yǎng)基上的單個(gè)菌落進(jìn)行革蘭氏染色,在電鏡下觀察可見(jiàn)革蘭氏陰性短桿菌,見(jiàn)圖2D。
圖 2 結(jié)菌分離培養(yǎng)結(jié)果
4.3、診斷結(jié)果分析
根據(jù)檢測(cè)結(jié)果判定發(fā)病豬為藍(lán)耳病繼發(fā)副豬嗜血桿菌病,表明藍(lán)耳病繼發(fā)副豬嗜血桿菌病是引起本次疫情的主要原因。
5、防治措施
1)及時(shí)隔離病豬,防止病豬與健豬接觸,同時(shí)采用大劑量的抗菌藥物進(jìn)行治療。
2)進(jìn)行藥敏試驗(yàn),根據(jù)藥敏試驗(yàn)結(jié)果選擇敏感藥物進(jìn)行防治,如鹽酸環(huán)丙沙星、頭孢曲松鈉、頭孢噻呋、克林霉素。
3)加強(qiáng)環(huán)境消毒和飼養(yǎng)管理,在發(fā)病期間堅(jiān)持每天消毒1次,同時(shí)保持欄舍通風(fēng),適當(dāng)減少飼養(yǎng)密度,減少應(yīng)激,加強(qiáng)生物安全措施,執(zhí)行全進(jìn)全出制度,嚴(yán)格消毒。
4)仔豬出生后用鹽酸頭孢噻呋(10mL/瓶)保健3針,預(yù)防斷臍、剪牙、斷尾、斷奶過(guò)程中因傷口或應(yīng)激引起的細(xì)菌感染:第1針于仔豬1日齡時(shí)肌肉注射鹽酸頭孢噻呋0.3mL/頭,速康注射液(干擾素,10mL/瓶)0.5mL/頭;第2針于仔豬7日齡時(shí)肌肉注射鹽酸頭孢噻呋0.5mL/頭,速康注射液0.5mL/頭;第3針于仔豬斷奶時(shí)肌肉注射鹽酸頭孢噻呋1mL/頭,速康注射液1mL/頭。
5)預(yù)防副豬嗜血桿菌的有效保健措施:①飼料中添加替米考星300 g/t+10%氟苯尼考500 g/t+強(qiáng)力霉素300 g/t,連用7d。②支原停(鹽酸沃尼妙林)按750 g/t拌料;阿莫西林按400 g/t拌料;磺胺類藥按100 g/t飲水。
(孫晶 黑龍江畜牧獸醫(yī)雜志社)
